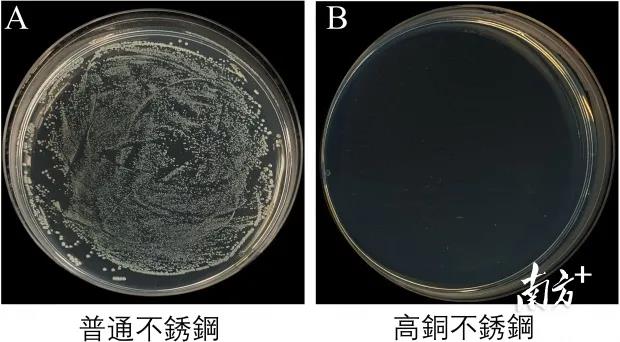

全球首个可杀灭新冠病毒的不锈钢是如何面世的?
不过在日前,香港大学也宣布一个好消息:该校工程学院机械工程系黄明欣教授团队,与港大李嘉诚医学院免疫与感染研究中心研究团队合作,研发出全球首个其自身表面可杀灭新冠病毒的高铜含量不锈钢。3小时杀灭病毒率可以达到99.75%,6小时之后杀灭病毒率可以达到99.99%,基本已经很难被检测到。
黄明欣教授在接受南方报业记者采访时详细介绍了此次项目的研发过程。他也表示,这次研发的新型不锈钢材料是利用铜离子的“杀毒”特性,属于物理方式“杀毒”,相信具有广谱性。目前研发团队正围绕新型材料对德尔塔和奥密克戎等变种病毒的杀灭作用进行测试,“我们认为应该是可行的,但需要等待实验数据验证”。
从杀灭甲型流感H1N1病毒到杀灭新冠病毒
黄明欣2002年和2004年从上海交通大学获得工程力学学士学位和固体力学硕士学位,于2008年从荷兰代尔夫特理工大学获得材料科学的博士学位。之后,他受聘于当时全球最大的一家钢铁企业在法国的全球研发中心从事汽车钢的研发工作。
“工作两年后,我觉得自己还是更喜欢做基础研究。刚好碰到香港大学机械工程系面向全球招聘,我就在2010年应聘了港大的助理教授。”因致力研究超强韧钢铁,黄明欣被称为“钢铁侠”,主要从事金属材料强韧化及相变研究、汽车轻量化超高强钢研发。到2019年,黄明欣已成为港大少数年轻的正教授之一。
此次研发一开始并不是瞄准新冠病毒。四年前,变种的甲型流感H1N1在世界上流行,一些幼儿园的小孩也有接触传染的风险。黄明欣的团队就想,过往很多人研究抗菌不锈钢,那能不能研发一种可以抗流感病毒的不锈钢材料?
有了想法之后,黄明欣带领团队开始着手研究,但还没等结果出来,2020年新冠肺炎疫情就暴发了。“所以我们把抗流感病毒不锈钢扩展到抗新冠病毒。”黄明欣告诉记者,当时他们已经跟港大医学院的生物安全防护三级实验室合作,可以开展抗甲型流感病毒、抗新冠病毒的实验。
不同于细菌,病毒结构是RNA。两者结构不同,团队的研究一开始也并不顺利。按黄明欣团队一开始的设想,用银抗菌是比较普遍的,但在实验中却发现纯银杀灭新冠病毒作用不明显。之后团队转换思路,尝试用铜来代替银,发现纯铜、高铜不锈钢是可以实现“灭毒”的作用。
铜含量如果太高,以后材料就会变脆,很难加工应用。含铜量不足,却没有“杀毒”效果。“那关键就在需要多少含铜量,以及如何将这个比例的铜冶炼为符合需求的钢材料。”团队通过调整不锈钢的化学成分和微观组织结构,再用一些特殊方法突破冶炼难题,在2020年暑假成功令不锈钢表面可以杀灭新冠病毒和其他常见的病原体微生物。
3小时病毒存活率仅剩0.25%
据黄明欣透露,此次研发出来的自身表面可杀灭新冠病毒的高铜含量不锈钢,3小时杀灭病毒率可以达到99.75%,相当于绝大部分病毒已经死亡,感染风险已经降到极低。6小时之后杀灭病毒率可以达到99.99%,基本已经很难被检测到。
不同于药物杀毒的方法,新型钢材料杀毒原理是铜离子的杀毒特性,属于一种物理方式。黄明欣表示,这种方式“杀毒”具有广谱性,除了可以杀灭甲型流感病毒、新冠病毒之外,后续他们还会继续做德尔塔和奥密克戎等变种病毒的测试。“我们认为应该是可行的,但需要等待实验数据验证。”
这款新型钢材料面世之后,已经有不少公司和港大技术转移处联系,其中也包括不少内地公司,希望得到专利授权。正如之前新闻发布会所讲,该款新材料将可应用在电梯按钮、扶手,甚至做一些穿戴用的电子产品等各种可与人体接触、又适合使用不锈钢材料的地方,从而减少使用者接触病毒的风险。
这次的新型钢材料,只是黄明欣众多科研成果之一。黄明欣被称为香港“钢铁侠”,其研究的新型钢铁材料离应用场景非常近。所以一直以来,他做的基础研究,尤其是一些高强钢,为钢厂、汽车厂解决了不少技术难题。例如前段时间黄明欣研发的一款1400兆帕级QP钢,就能在不牺牲安全性的前提下,让汽车重量较传统的减少10%。
“要知道钢铁产业已经很成熟了,越往前越难,所以每个百分点都是进步。以前我们强调节能减排,通过为汽车‘减重’就可以减少耗油量、排放量。而随着‘双碳’目标的提出,未来这方面研究还会有更大的前景。”黄明欣说。
国家、广东省对香港研发的支持逐渐增多
国家“十四五”规划提出支持香港建设国际创新科技中心,香港也在加快发展科创来优化经济结构,其中一大优势就是香港拥有的优秀大学资源和基础的研究能力。
作为高校研发人员,黄明欣也感觉到这几年香港科创发展的变化,尤其是政府和社会对科研投入的加大。“我刚来香港那会,政府支持研发的经费相对较少,但这几年科研经费渠道明显在拓宽,港府的科研投入也在增加,包括这次的项目就获得了香港研究资助局的赞助。”更让黄明欣兴奋的是,这几年国家支持科研的经费申请也对香港研究人员开放了。
“我本身就有项目得到了科技部的支持,其中一个还是上千万元级别的。”黄明欣手头上还有项目是跟广州市、深圳市合作的,“感觉随着粤港澳大湾区的建设,类似的支持还会越来越多。”
谈到香港对科创人员的支持,黄明欣在很多采访场合都会提出一个建议:“就是政府对引进的高技术人才要有支援政策,降低他们在港生活的成本。”黄明欣告诉记者,他身边有很多来自国外的同事,把国外的房子卖了想到香港安家发展。但由于不懂香港的政策,很多教授、院士来到香港之后才发现,非香港永久居民购房需要支付30%的税费。
“香港想吸引高技术人才,但是税费政策却给这些愿意来的人设置了障碍,这其实是矛盾的。”据黄明欣分析,无论内地城市还是其他国家,甚至是对移民比较保守的北欧国家,都有优待高技术人才的减税政策,甚至比本地居民还要优待。“但香港这方面偏偏相反,这是不利于吸引人才的。”
下一篇:返回列表




